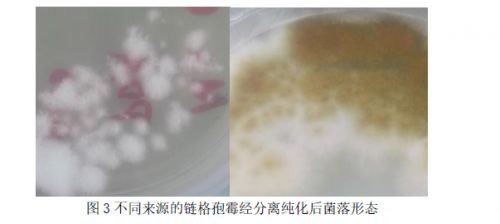
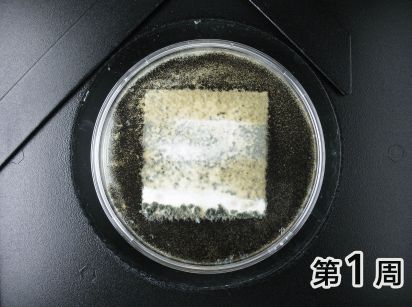

专家详解如何提升地下车库等潮湿空间“防霉力”
梅雨季又将近,多雨潮湿的华南又将迎来墙面发霉的高发期。在相对封闭、欠缺通风的地下空间,更是霉菌滋生的“重灾区”。作为住宅和商业项目的重要基础配套,以及用户对建筑品质感的“第一眼印象”,地下停车库应如何做到科学防霉?

为地下车库做好科学防霉 为“第一眼大堂“的品质感加分
本期专家讲堂,立邦工程将联合杜邦微生物控制技术专家为您带来详细解读。
地下车库霉菌污染为何防不胜防?
霉菌是丝状真菌的俗称,可以在很多材料上形成肉眼可见的绒毛状或蛛网状菌落,还可以产生细小的霉菌孢子进行空气传播,在环境中广泛分布。杜邦微生物控制技术部林楹博士在介绍地下车库墙面霉菌污染情况时表示,地下车库墙面的霉菌污染一直是困扰行业多年的难题。地下车库因具备湿度较大、通风较差、温度适宜、可能出现渗水或者雨水侵入等条件,是建筑物中最适合霉菌生长的环境之一。
录音:杜邦微生物控制技术专家林楹博士 地下车库墙面霉菌污染问题严峻
墙面涂料因含聚合物乳液等有机物,可为霉菌生长提供营养,是地下车库霉菌侵蚀的主要目标。特别是近年来,随着行业内从溶剂型涂料到水性涂料的转型,在环保性能提升的同时,却无形中降低了涂料的防霉性能,也是地下车库屡见霉菌污染的原因之一。此外,因环境因素和施工质量等问题,有些地下工程在还没有完工时,或在未交付使用时就出现大面积涂层霉变,霉变面积可达总面积的2/3。

潮湿、难通风的地下停车库 是墙面霉菌滋生的重灾区(图片来自网络)
近年来,立邦工程与杜邦微生物控制技术专家组对华东主要省市的多个地下车库的发霉墙面进行调查采样,采样地点墙面的涂装时间从2008年到2012年不等,采样时间多在5-8月梅雨季节过后,环境相对湿度达65%~95%,温度和湿度最适合真菌生长以及真菌出现最多的时候,其中包括一个涂装仅一个月就出现大面积漆膜霉菌污染的地下车库项目。
录音:杜邦微生物控制技术专家梁爽 调查地下车库墙面霉菌取样过程
62个采集样品,涉及多种品牌涂料,其中不乏应用了防霉内墙涂料的样品。专家组通过对样品中的霉菌进行增殖、分离纯化,并进行DNA测序鉴定霉菌菌种,来溯源分析霉菌在地下车库频繁出现、防不胜防的原因。

华东地区地下车库墙面采样 霉菌污染非常普遍
这些霉菌为什么不怕普通防霉涂料?
经过对采样的霉菌种类鉴定,专家组发现除了常见的青霉、曲霉、出芽短梗霉和绿色木霉等霉菌种类以外,漆膜霉菌污染中出现概率较高的还有现行国标《GB/T 1741—2007 漆膜耐霉菌性测定法》中,只在外墙涂料实验中使用的链格孢霉。
不同来源的链格孢霉经分离纯化后的菌落形态
链格孢霉在环境中非常常见,是农作物、水果中出现较多的霉菌种类,它可以随着空气传播,进而污染墙面涂料。墙面上霉菌污染会产生霉斑、影响美观;霉菌的生长还会破坏漆膜及基材的结构,严重时造成漆膜开裂、剥落等;同时霉菌生长还会产生异味和毒素,降低室内空气质量并危害健康。

显微镜下链格孢霉菌丝和孢子形态
调查表明,GB/T 1741—2007中的内墙涂料防霉测验中,未见对最常见的链格孢霉的检测,普通防霉涂料所采用的传统防霉剂仅对GB/T 1741—2007中所列霉菌起到抑制作用,所以,即使是通过了现行国标测验的合格防霉涂料,依然可能因缺少对链格孢霉的防范抑制而导致防霉失败。
(GIF动图)
普通防霉涂料在GB/T 1741—2007中防霉性能达到1级 但未能通过含有链格孢霉的防霉测验
如何科学防霉?种类扩容强效抑霉
之所以发起这项调查研究,也是源于立邦工程项目服务团队在接触客户的过程中,发现地下车库经常出现的墙面霉菌污染问题。

地下车库屡见霉菌污染 原因多多
据杜邦微生物控制技术部专家梁爽介绍,立邦与杜邦在研究中经过不断地优化、调整、测验,根据调研结果对现行国标防霉测验方法进行了强化,在测验霉菌效果时选用更具代表性的测验霉菌种类,加强了对涂料防霉广谱性的要求。实验中增强了测验中霉菌生长的旺盛程度,用于模拟恶劣环境中霉菌生长情况。,引入候化条件,模拟地下车库潮湿环境对涂料防霉的挑战,并最终优化出更广谱、强效的防霉涂料配方。
录音:杜邦微生物控制技术专家梁爽 改良防霉测验方法提升防霉性能
新型的强效防霉内墙涂料在水中溶解度极低,在潮湿阴暗或日晒雨淋的环境下都有极强的长效保护性,可更有效提供广谱防霉保护,再也不怕“超纲”霉菌侵害地下车库墙面。

(GIF动图)
应用强效防霉剂的涂料样板 顺利通过含有链格孢霉的防霉测验
点滴霉菌,对建筑项目,对人身健康的影响不可忽视。要促进健康建筑高品质发展,推进行业标准的与时俱进同样重要。
扫描二维码,查看立邦联合杜邦微生物控制技术专家(原陶氏化学) 共同发布的《地下车库墙面霉菌污染状况及防霉性能测验选择》论文。
梅雨季将近,科学防霉早准备,立邦与您共同守护建筑健康。
杜邦微生物控制技术部简介
杜邦微生物控制技术部是原陶氏化学旗下主营防腐、防霉、抗藻剂的业务部门。近50年来,先后收购、合并包括罗门哈斯在内的9家世界知名公司的杀菌剂事业部,形成今天的杜邦微生物控制技术业务部,是全球工业生产制造商最大最杰出的微生物控制技术合作伙伴。在全球范围拥有12个微生物控制客户应用中心、3个研发中心,其中一个研发中心就位于上海。作为杀菌剂活性成分注册的领导者,杜邦微生物控制技术部拥有最多的杀菌剂活性成分(包括一些独有高效活性成分)、一流的配方经验、卓越的全球法规支持和毒理学研究能力。
网址:专家详解如何提升地下车库等潮湿空间“防霉力” https://c.jiaju82.com/news-view-id-704250.html

